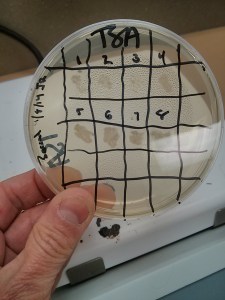
One of the student pick-and-patch masterplates

Me taking a picture of the envelope taped to the front door before leaving Friday evening. Just in case.
When I wrote the previous post about my anxiety regarding the PCR reaction of the soil cultures, I did not explain the main reason for it: this was to be part of an actual laboratory class. Those of us who teach lab classes know the feeling of slight embarrassment when things go awry. You expect a reaction that does not happen or the microbes don’t look the way they should. Reasons abound: from human mistakes and carelessness to expired reagents, bad batches, or plain biology. Sometimes it can be made a teachable moment, but not always.
So last Thursday I went to the lab hours earlier and did a mock run, which was a good idea, because I made a number of mistakes, one being walking away after pressing the Start button. Turns out the machine wanted me to press an additional OK, then asked about 2 more settings, and finally made me confirm that I was ready to run. Luckily after half an hour I had started wondering why the machine was so quiet. Duh.
By the time the students rolled in I was feeling much better, and after pipetting the reagents of the first tubes, I asked for volunteers. There were several, and as they were enthusiastically pipetting the 1 ul volumes I started wondering if that was a good idea. None of those students had ever used a micropipette before.
But they were delighted and enthusiastic, something that all participants of the Small World Initiative have reported. Ownership of a project comes hand in hand with motivation, and once the tubes were in the machine and the students returned to their plates it was a joy to watch them discussing their soil isolates.
When I ran the electrophoresis the next morning, I was a bit disappointed but not surprised. One lane had a clear band, some had faint bands, and the rest were smeary. As I expressed to one of the students the day before: we want the first experiment to work, but not perfectly so we can improve it for the next time. A first flawless experiment is almost always a fluke, and we cannot learn from it.
So I ran the samples again, this time in the blessed quiet of the lab. Things looked much better. I called the company that would do the sequencing, and scheduled a pickup around 2 pm. Put the samples in an envelope, left them at the front desk, and went on with my things. At 5 pm, the envelope was still at the front desk. Called the company, and they told me the courier was on its way. “LA traffic, you know.”
Our building closes at 6 pm, as the receptionist dutifully reminded us around 5.50 pm. The envelope had not been picked up. I was leaving town next morning, and started panicking. Three frantic phone calls later somebody picked up the phone at the company. I explained that the building would be locked in minutes, and was advised to tape the envelope to the front door. At 6.30 pm, I had to leave with a heavy heart.
Next morning I had not received any emails or calls concerning envelopes taped to the front door, so I assumed things were under control. It was in LAX 10 minutes before boarding the plane that the email rolled in: Please log in to see your sequences…
The next few minutes were almost rapturous. I logged in and discovered the majority of the sequences were “great” or “ok.” Few had issues. Knowing that students were using the long weekend to work on their poster presentations and they needed the data, I frantically copied and pasted the sequences into a document and sent them away before boarding the plane.
It was not until late in the evening that I was in internet range again. First I ran a sample I had sequenced before and used as a control. The hotel wifi was a bit sluggish, but Blast finally came back with the correct result: Pseudomonas. I almost hollered.
The sequences came out interesting- some expected genera, others less expected. It will be interesting to see how the genetic data compare with their traditional microbiology tests.
I am happy.